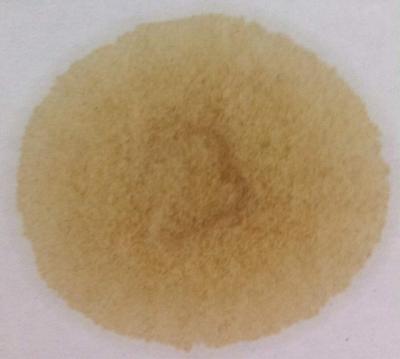
Attached Image
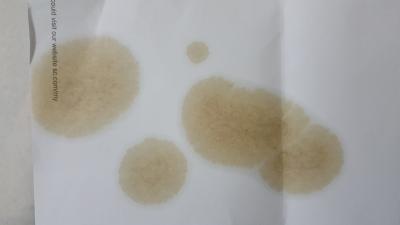
Attached Image

..............................................................................................
What do you think ?

https://bobistheoilguy.com/forums/threads/c...0-miles.264501/
A1.1) Round 1: Total Quartz 7000 Energy 10W40 SL/A3B4 in 2005 Avanza 1.3L K3-VE
A1.2) Blotters for :12,238 km ; 13,000 km ;13,673 km ; 14,218 km and 16,593 km
Note:Finally oil change at 16,631 km (10,334 miles) in early May 2017 after 9 months in use.
Fuel in use:
Mostly use : (Brand/RON#) BHP RON 95 ;
Mixed with : (Brand/RON#) None
A2.1) Round 2: Total Quartz 7000 Energy semi synthetic 10W40 SL/A3B4 in 2005 Toyota Avanza 1.3L K3-VE
A2.2) Blotters for : 5,087 km; 8,665 km ; 10,616 km ; 13,478 km and 15,000 km
Note:On 31 Jan 2018,after 9 months in use,this oil is replaced by fullsyn Shell Helix Ultra 5W40 MB 229.5
A3.1) Round 3: Shell Helix Ultra Full Synthetic 5W40 A3B4,MB 229.5,LL01,VW 50200 50500 in 2005 Toyota Avanza 1.3L K3-VE
A3.2) Blotters for :5575 km;10099 km;14100 km ;17138 km
A4.1) Round 4: Mobil 1 New Life 0W40 (Tesco) MB 229.5,LL01,VW 50200 50500 in 2007 Toyota Avanza 1.3L K3VE
A4.2) Blotters for :9642 km;13021 km;14306 km -engine parts replacement ; ODO 294k km ;
A5.1) Round 5: Mobil 1 New Life 0W40 (Tesco) MB 229.5,LL01,VW 50200 50500 SN in 2007 Toyota Avanza 1.3L K3VE :-
A5.2) Blotters for :12,367 km ;15,795 km ;17,335 km ;18,031 km ; 19,160 km ;20,183 km ODO 314k km ;
A6.1) Round 6: Mobil 1 New Life 0W40 (Tesco) MB 229.5,LL01,VW 50200 50500 SN in 2007 Toyota Avanza 1.3L K3VE :-
A6.2) Blotters for : 8,784 km; 11,080 km;15,229 km ODO 329k kms;
E1 )Total Quartz 7000 Energy 10W40 semisyn SL A3B4 in 2007 Avanza 1.3L K3VE MPI :-
a) 16,593 km ODO 247k km ;
b) 15,000 km ODO 262k km .
Aisin
5W30
a )Aisin FS 5W30 (non-PAO)
1 )7401 km;11400 km;13536 km; 14990 km in 2002 Hyundai Elantra 1.8L G4GB @alphaz;
2 )8100 km ODO 144,000 km in 2011 Honda City @ cempedaklife;
b )Aisin evoTECH FS PAO+Ester 5W30 Mid-SaPS* PDS
1 )1,800 km ODO 137K km, in 2014(?) Proton CamPro CFE turbo @Andy0625 ;
2 )2,243 km, 7,456 km ODO 145K km, in 2009 Honda City GM2 @La2yboy/90Boyz ;
5W40
a )Aisin FS PAO+Ester 5w-40 SN Mid-SaPS* PDS
1 )12000 km in Elantra 2.0 NA (G4GC),ODO 194k km @speedy3210;
2 )12000 km in 2008 Toyota Vios NCP93 ODO 241k kms @shimiky;
Amsoil
5W30
a )Amsoil Signature Series ASL 5W30 SN D1G2 A5B5 Ford M2C-946-A
1 )2907 km ; 6912 km ;10,006 km ODO 132K km in 2009 Honda City GM2 @90Boyz;
Bardahl
5W40
a )Bardahl MXP 5W-40 FS
1 )4322 km, ODO 173k;6829 km, ODO 180k in Nissan Livina 1.6 NA @ putra23
Castrol
5W30
a )Castrol Magnatec Stop-Start fullsyn 5W30 of SN A3B4 PDS
10W40
a )Castrol Magnatec 10W40 SN
1 )1537 km, ODO 234k km in 1999 Proton Wira 1.3 Fuel Injection @BravoZeroTwo
20W50
a )Castrol GTX 20W50 SL
1 )5200 km,6000 km ODO 54.5k km in 2016 Toyota Estima 2.4L 2AZFE engine @tchinhe;
Honda
0W20
a )Honda Genuine Engine Oil HGEO Fully Synthetic 0W20 SN
1 )10200 km in 2014 Honda City GM6 Non-hybrid @boxer07;
0W30
a )HGEO Fully Synthetic 0W30 SN
1 ) 3000 km;4000 km ODO 101,000 km in 2011 Honda City @ cempedaklife;
2 ) 3750 km ODO 107750 km -------------------ditto--
3 ) 7110 km ,Before seafoam 7989 km and After seafoam 8109 km ODO 121,358 km --ditto--
4 ) 3222 km; 4622 km in 2010 Honda City L15A7,ODO 103k km @ Thrust;
5W30
a )Honda HGEO Semi Synthetic 5W30 SN:
1 )6797 km 4.5 years oil life in 2003 Honda City iDSI ,ODO 57,506 km @ Trony;
2 )2330 km in 2009 Honda City GM2 , ODO 136k km @ 90Boyz ;
b )Honda HGEO Semi Synthetic 5W30 SP -silver:
1 )7780 km in 2009 Honda City GM2, ODO 163k km @90Boyz;
Kaito
5W30
a )Fully synthetic 5W30
1 )1172 km in 2006 Myvi Auto MPI NA, ODO 199k km @abubin;
Kixx
0W30
a )Kixx PAO 1 0W30 (100% Synthetic) SN CF , MSDS ;
Liqui Moly
5W30
a )Liqui Moly fully synthetic 5W30 Special Tec AA
1 )11000+ km in Honda K20A @unitron;
2 )3,000 km Odo 130k km in 2011 Honda City @ cempedaklife ;
5W40
a )Liqui Moly Top Tec 4100 5W40 C3 SN MB229.31 VW 50500 50501 Porsche A40
1 )10,000 km in 20xx Toyota Avensis (Russian) 2.2L Diesel Common Rail D-4D engine @Russian;
Mannol
10W40
a )Mannol Diesel Extra 10W40 CH-4/SL semi synthetic
1 )8325 km,9771 km,11000 km ODO 308k, in Nissan AD Resort 1.6L GA16 carburettor @chemistry;
Mizu
5W30
a )Mizu Fully Synthetic 5W30 SN PDS
1 )2582 km ODO 196k kms, in Myvi 1.3L @abubin;
Mobil
5W30
a )Mobil 1 ESP 5W30 SN C3 MB229.52 VW50400 50700 PDS
1 )7000 km in TGDI engine @ therain01 ;
2 )3200 km; 7,800 km ; ODO 86K km, in 2014 Honda CRV 2.4L engine MPI @ dopamine ;
b )Mobil 1 EP 5W30 SN+ GF5 GM D1G2 A5B5 Ford M2C946A SA=0.8%; PAO=20-30%; PDS;
1 )7000+ km ODO 98k+ km in Mazda3 2.0L SkyActiv DI @ incredibless
0W40
a )Mobil 1 New Life 0W40 SN A3B4;VW50200 50500;Porsche A40
1 )3000 km in TGDI engine @ therain01
2 )9642 km;13021 km;14306 km ODO 294k km in 2007 Avanza 1.3 MPI @zeng
3 )12,367 km ;15,795 km ;17,335 km ;18,031 km ;19,160 km ;20,183 km ; ODO 314K km in 2007 Avanza 1.3L MPI @zeng;
4 )8,784 km; 11,080 km;15,229 km;17,080 km ODO 331k kms in 2007 Avanza 1.3L K3VE MPI @zeng;
10W40
a )Mobil Super 2000 X2 10W40 semi-synthetic SN A3B3;MB 229.1
1 )4000 km ODO 84k km in 20xx CamPro VVT MPI @ OvenBaked
15W40
a )HDEO Mobil Delvac mineral MX 15W40 (CJ4)
1 )740 km,20 hours of track time in KTM RC390 Motorcycle @e-lite;
Nissan
10W40
a )Nissan Total Quartz Energy 7000 10W40 SL A3B4 semi-synthetic
1 )2200 km ;ODO km in 1987 Volvo B230E SOHC 2316 cc MPI, Automatic Trans @Benck ;
Pennzoil
5W40
a )Pennzoil Platinum Velocity 5W40 100%-synthetics
1 )9000 km;9900 km;17000 km;22000 km ODO 91k kms in 2014 Myvi 1.3L Auto K3VE EFI @Senscents;
Perodua
0W20
a )Perodua FS 0W20
a )6161 km ,ODO 43K km in 2018 Myvi D20N 1.5L 2NR-VE engine @Blank19
5W30
a )Perodua SS 5W30 SM gold bottle
1 )5000 km, ;7000 km;8000 km,ODO 133k in Kenari 1.0L @ahsam1212;
PetroCanada
0W30
a )HDEO Petro Canada Duron XL 0w30 (API CH4/SJ) synthetic blend
1 )10912 km;12707 km ODO 283k, in Nissan AD Resort 1.6L GA16 carburettor @chemistry;
15W40
a )HDEO Petro-Canada Duron semi synthetic SHP 15w40 (CK4,E9,ECF-3)
1 )11145 km ODO 295k ;12558 km ODO 297k, in Nissan AD Resort 1.6L GA16 carburettor @chemistry;
Petronas
5W30
a )Petronas Syntium 3000 FR 5W30 SN A5B5 Ford WSS-M2C-913D
1 )11680 km ODO 95680 km, in 2014 Kia Rio UB 1.4L Gamma MPI G4FA @90Boyz ;
2 )2388 km ODO 94K km, in 2007 Suzuki Swift 1.5L MPI @ dopamine ;
3 )5,218 km ODO 130K km, in 2014(?) Proton CamPro CFE turbo @Andy0625 ;
b )Petronas Syntium 3000 5W30 SN+ GF5 Dexos 1 Gen 2 Mid-SaPS* (Malaysia version) PDS
1 )6000 km ODO in MB GLC250 @jamespaul;
2 )2000 km ODO 245K km in 200x Perodua Viva 660 cc @ PointOfSale ;
3 )500 km ODO 144K km in 2005 Myvi 1.3L K3VE @ PointOfSale ;
4 )6,500 km ODO 123k km in Mazda3 2.0L SkyActiv @ incredibless ;
5 )2,000 km ODO 303k km in Honda City Idsl @ jin manusia ;
6 )3,000 km, 6000 km ODO 136k km in 2015 Proton Campro IAFM @clockpulses ;
c )Petronas Syntium 800 5W30 SN GF5 PDS
10W30
a )Petronas Syntium 800 10W30 SL GF3 A3 PDS
10W40
a )Petronas Syntium 800 SS 10W40 SN A3B3 MB 229.1 PDS
1 )4181 km ODO 189k km , in Toyota Vios NCP 42, Engine: 1NZ-FE @XinG;
2 )1000 km ODO 67k km , in Campro VVT engine MPI @OvenBaked ;
15W40
a )Petronas Urania 3000 LS 15W40 Mineral HDEO CJ4 E9 Mid-SaPS* PDS
1 )5000 km ODO 60k km, in 2016/7 Proton Persona/Saga 1.3/1.6 CamPro VVT @OvenBaked ;
Schnell
5W40
a )Schnell Ultimate II Fully Synthetic 5W40 SM MB229.3 (German)
1 )7000 km ODO 140k kms in 2004 Toyota Vios Gen1 @mushigen;
Shell
0W30
a )Shell Helix Ultra ECT C2/C3 0W30 SN C3 MB229.52 VW504 PDS
1 )10500 km;12000 km in Mazda6 2.2L Diesel twin-turbo @rcracer;
b )Shell Helix Protect 0W30 API SN+ ACEA A3/B4
1 )4810 km; 10,081 km ODO 35,877 km, in 2019 Hilux Revo 2.4G 2GD-FTV Auto @Gin87;
2 )9,596 km 31 months old ODO 85,111 km in 2014 Myvi Lagi Best 1.5L 3SZ-VE @Gin87;
5W30
a )Formula Shell 5W30 SN GF5 PDS1;PDS2
1 )8500 km ODO 323k in 1997 Wira 1.5 auto 4G15 carburrettor @Senscents;
2 )9200 km ODO 70k, in Mazda3 @wkc5657;
b )Shell Helix Ultra Fully Synthetic 5W30 A3B4 (Made in Hong Kong)
1 )10060 km; 14160 km ;15999 km in 2002 Hyundai Elantra 1.8L G4GB @alphaz
c1)Shell Helix HX8 Fully Synthetic 5W30 SN PDS OEM MB 229.5 (between Jan 2020 and Aug 2021)
1 )100 km (est),after changing out seafoam, ODO 121k km in 2011 Honda City @ cempedaklife;
c2)Shell Helix HX8 X Fully Synthetic 5W30 SN acquires OEM MB 229.5 approval (between Jan 2020 and Aug 2021)**
1 )1069 km,3155 km,6279 km,8168 km,10094 km, 11933 km ODO 121k, in 2009 Honda City Gm2 @90Boyz;
2 )5873 km; ODO 153k kms in 2009 Honda City Gm2 MPI @90Boyz;
d )Shell Helix HX7 semi synthetic 5W30 SN A3B4
1 )7400 km ODO 60890 km , in Mazda3 @wkc5657
5W40
a )Shell Helix Ultra 5W40 SN MB 229.5 A3B4 PDS
1 )1020 km ;10,814 km ,ODO 170K km in 2008 Toyota Vios 2nd gen Dugong @ tanalvis ;
2 )5575 km;10099 km;14100 km ;17138 km ODO 280k km in 2007 Avanza 1.3L K3-VE MPI @zeng ;
3 )10,300 km ,ODO 170k km in Proton Inspira 2.0L @ahsam1212 ;
4 )12602 km, ODO 283k km in Hyundai Elantra 2.0L NA (G4GC) @speedy3210;
5 )14184 km, ODO 380740 km in 2007 Avanza 1.3L K3-VE MPI @zeng;
b )Shell Helix HX8 Synthetic 5W40 SN A3B4 MBB229.3 PDS
1 )
10W40
a )Formula Shell 10W40 mineral SN PDS
1 )5466 km ODO 395k km, in 1999 Wira 1.6 MPI @speedy3210;
20W50
a )Shell Helix HX3 20W50 SL
1 )400 km in 1994 Mercedes Benz S600 6.0L V12 M120 SFI sequential fuel injection @90Boyz;
Tech Plus (Aeon Big)
5W40
a )Tech Plus Full Synthetics 5W40 SN
1 )5200 km in 2007 Myvi 1.3L K3VE @zeng;
Total
10W40
a )Total Quartz Energy 7000 10W40 SN A3B4
1 )2600 km ;ODO km in 2000 Honda Accord S86 F23A (2254 cc) SOHC VTEC @Benck ;
2 )7500 km; 9500 km without ACEA A3B4(?), ODO 180k kms in 201x Proton Inspira @ahsam1212 ;
Toyo
10W40
a )Toyo Semi Synthetic 10W40
1 )2000 km ODO 155K km in 201x Proton Satria Neo @ SKY233 ;
Toyota
0W20
a )Toyota Fully Synthetic 0W20 SN GF5
1 )3262 km ODO 180k km in Gen 3 (2010-2015) Toyota Prius Hybrid 1.8L @abubin;
Zic
5W30
a )X7 full synthetic 5W30 SN GF5
1 )4500 km ODO 84k km , in 2009 Nissan Latio C11 1.6L @yuareblessed ;
* denotes Mid-SaPS oils.
.................................................................................................................................................
FAQ engine oils
1 )Severe Usage Service, definition by Proton Campro;
..................................................................................................................................................
ATF Blotters
Penrite ATF FS Multi Vehicle PDS
a )21087 km ODO 146k kms in 2009 Honda City TM0 AT 5speed Auto transmissions;
Toyota Type IV
a )32138 km;18,896 km (with ATF oil treatment) ODO 325k kms; in 2007 Toyota Avanza 1.3 automatic transmission;
....................................................................................................................................................
API Sx Specification launching chronology
from pre-1930 (API SA) till todate (API SP).
....................................................................................................................................................
Product Technical Data Sheets PDS/TDS :
Castrol
1) Magnatec Stop-Start fullsyn 5W30 SN A3B4 ;
Mobil
1) Mobil 1 ESP 5W30 SN MB229.52 VW504 507 ;
2) Mobil 1 EP 5W30 SN Plus D1G2 A5B5 ;
Petronas
1) Syntium 800 10W30 SL GF3 A3 ;
2) Syntium 800 5W30 SN GF5 ;
3) Syntium 800 10W40 SN A3B3 ;
4) Urania 3000 LS 15W40 CJ4 E9 ;
5) Syntium 3000 5W30 SN Plus GF5 D1G2 ;
6) Syntium 3000 SE 5W30 SN GF5 ;
7) Syntium 3000 FR 5W30 SN Ford WSS-M2C-913-D A5B5 ;
Shell
1) Formula Shell FS Conventional 5W30 SN GF5 ;
2) Formula Shell Conventional 10W40 SN ;
3) Helix HX8 5W30 SN MB229.3 ;
.................................................................................................................................................
VOA:
VOA Amsoil SS 5W30 ASL GM D1G2 Ford M2C946-A A5B5 Full Synthetic
VOA Liqui Moly Ceratec (Oil Treatment)
VOA Shell Helix HX8 5W30 SN MB229.3 Full Synthetic
VOA Shell Helix HX7 5W30 SN MB229.3 Semi Synthetic
VOA Shell Formula 5W30-1;-2
VOA Shell Helix Ultra 5W40 (Russia) Full Synthetic
................................................................................................................................................
UOA:
UOA Chevron Delo Sports Synthetic Blend 10W30 CI4 10,000 km in 201x(?) Ford Ranger 2.2D (Credit to @e-lite);
UOA Idemitsu Zepro Adv Moly 0W20 SN 5136 km in 2011 Toyota Prius Hybrid 2ZR-FXE 1.8L Odo 304k kms;
UOA Mobil 1 EP 5W30 11,400 km in 2006 Mazdaspeed3 MZR 2.3L DISI Turbo L3-VDT ;
UOA Toyota Genuine Motor Oil 0W20 5000 miles in 2015 Toyota Lexus LX570 ;
...................................................................................................................................................
Z) Further readings:
Blotter Spot Test Helps Improve Engine Reliability
Sample Preparation and Test Procedure: A Quick Guide
New Method for Evaluating Lubricant Dispersancy
Blotter Spot Testing for Metallic and Other Solid Particles
How to Spot Check Your Car's Oil
Chromatogram Patterns
Motor Oil Analysis Testing On The Cheap
ASTM D7899
Condition-based Lubricating Oil Change
Simple Oil Blotter Test
Blotter Spot Testing for Metallic and Other Solid Particles , Fitch, Jan-Feb 2019 Machinery Lubrication
Get Ready For More Soot In Engine Oil / (Link)
Checking engine oil using the Oil Stain method Russia
Oil - when to change oil? Part 1 Russia
Oil - when to change the oil. Part II. Stains Russia
When to change the oil. Part III. Russia
Engine Oil Coefficient of Friction increases as Molybdenum additive in ppm decreases
Replace cooler and crank oil seals, mountings and ori O2 sensor (2005 Avanza 1.3L) in Sept 2019
One Drop Instant Lubricant Test
On Site Oil & Fluid Analysis
This post has been edited by zeng: Jul 31 2024, 10:29 PM


 Feb 8 2017, 02:03 AM, updated 6 months ago
Feb 8 2017, 02:03 AM, updated 6 months ago
 Quote
Quote

0.5708sec
0.5708sec
 0.45
0.45
 6 queries
6 queries
 GZIP Disabled
GZIP Disabled